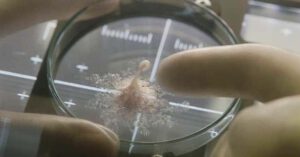

Por Mundo Esotérico y Paranormal
La amenaza de Andrómeda (The Andromeda Strain) es una novela escrita por Michael Crichton 1969 que en la actualidad se sigue recordando por el actual deleite narcisista de los países con sus respectivos programas espaciales.
Al tratarse de un satélite de investigación que regresa a la Tierra mortalmente contaminado, rara vez ha existido un libro tan adecuado en el momento adecuado.
Crichton fue un célebre escritor, guionista, director y productor de cine estadounidense, y se han adaptado variedad de éxitos de la ciencia ficción como Jurassic Park o Westworld, lo que le llevó a ser considerado todo un visionario de nuestro futuro.
La amenaza de Andrómeda cuenta la historia de cómo un grupo de científicos trabaja en un centro secreto de investigación de bacterias subterráneas de cinco pisos en Nevada. Su objetivo es identificar y neutralizar un virus letal traído de la atmósfera superior por un satélite que se ha estrellado en medio del desierto de Arizona.
No es necesario decir que en el momento que nos encontramos en la actualidad, con innumerables misiones espaciales y una pandemia, su novela está teniendo un renovado interés.
Pero tal vez, La amenaza de Andrómeda sea mucho mas que simple ciencia ficción. La NASA ha anunciado el descubrimiento y aislamiento de cuatro cepas de bacterias en diferentes lugares a bordo de la Estación Espacial internacional (EEI), tres de las cuales son complemente desconocidas.
Microorganismos de origen extraterrestre
Un nuevo estudio publicado en la revista científica Frontiers muestra que investigadores estadounidenses e indios que trabajan con la NASA han descubierto cuatro cepas de bacterias que viven en diferentes lugares de la EEI, hasta ahora, completamente desconocidas para la ciencia.
La mayoría de los microbios se identificaron en 2015 y 2016: uno se encontró en un panel superior de la estación de investigación de la EEI; otro en la Cúpula, área de observación y trabajo para la tripulación de estación espacial; y el tercero apareció en la superficie de la mesa del comedor de la estación. El cuarto se encontró en un antiguo filtro de aire HEPA que regresó a la Tierra en 2011.

Las cuatro cepas pertenecen a una familia de bacterias que se encuentran en el suelo y el agua dulce. Estas bacterias participan en la fijación de nitrógeno y el crecimiento de las plantas, y pueden ayudar a combatir los patógenos de las plantas.
Hasta el momento no se sabe cómo los microrganismos llegaron a la EEI, pero una teoría es que los astronautas que viven en la estación espacial han estado cultivando pequeñas cantidades de alimentos durante años, por lo que no es extraño que los científicos hayan encontrado a bordo microbios relacionados con las plantas.
Los autores del estudio secuenciaron genéticamente los microbios y encontraron que tres de ellos pertenecían a la misma especie de bacteria no identificada previamente.
Las tres cepas se denominaron IF7SW-B2T, IIF1SW-B5 e IIF4SW-B5. Identificaron la cuarta cepa, el hallazgo del filtro HEPA, como una especie microbiana conocida llamada Methylorubrum rhodesianum.
El equipo de investigación, dirigido por Swati Bijlani, un genetista de la Universidad del Sur de California, ha propuesto llamar a la nueva especie de bacteria Methylobacterium ajmalii en honor a Ajmal Khan, un renombrado científico de la biodiversidad de la India.
Esta nueva especie está estrechamente relacionada con una especie existente llamada Methylobacterium indicum.
Pero los investigadores no se mostraron preocupados sobre el verdadero origen de los microrganismos, ya que teniendo en cuenta que estos microbios pueden sobrevivir a bordo de la EEI, el equipo de Bijlani se propuso identificar qué genes de cada una de las cuatro cepas de bacterias podrían usarse para ayudar a promover el crecimiento de las plantas en las condiciones de baja gravedad del espacio.
“Esto ayudará aún más en la identificación de determinantes genéticos que podrían ser potencialmente responsables de promover el crecimiento de las plantas en condiciones de microgravedad y contribuir al desarrollo de cultivos de plantas autosostenibles para misiones espaciales a largo plazo en el futuro”, afirman los autores del nuevo estudio.
El equipo descubrió que una de las cepas, IF7SW-B2T, tenía genes involucrados en el crecimiento de las plantas. Uno de los genes de IF7SW-B2T ayuda a codificar una enzima esencial para producir citoquinina, una hormona vegetal que promueve la división celular en raíces y brotes.
Los investigadores dijeron que apenas han revisado la superficie de la diversidad microbiana en la estación espacial y ya se han recolectado alrededor de 1.000 muestras en la EEI, pero aún están esperando regresar a la Tierra.
Michael Crichton ya nos avisó sobre lo que podría pasar con las misiones espaciales, pero parece ser que no aprendemos. No solo estamos “colonizando” otros planetas, sino que además traemos microorganismos de origen desconocido. Además, esta no es la primera vez que descubren extrañas presencias en la EEI.
En 2017, el ingeniero ruso Anton Shkaplerov descubrió microorganismos que no estaban en el exterior de la Estación Espacial Internacional en su lanzamiento en 1998 y que “volaron desde algún lugar del espacio”.
Las bacterias fueron llevadas a la Tierra para su posterior estudio después de que las pruebas iniciales a bordo de la estación espacial mostraron que eran inofensivas para los humanos.
Esperamos que por nuestra propia supervivencia los científicos sepan lo que están haciendo. Ya que de lo contrario nos podríamos encontrar con virus y bacterias de origen extraterrestre invadiendo nuestro planeta silenciosamente.
Y esta posibilidad no es ninguna locura, ya que tal como dijo el profesor Chandra Wickramasinghe, astrofísico británico del Centro de Astrobiología de Buckingham, el coronavirus apareció en nuestro planeta a través del fragmento de un cometa que arrojó “cientos de billones” de partículas virales.
¿Están haciendo lo correcto los científicos, trayendo microorganismos extraterrestres a nuestro planeta?

Deja una respuesta